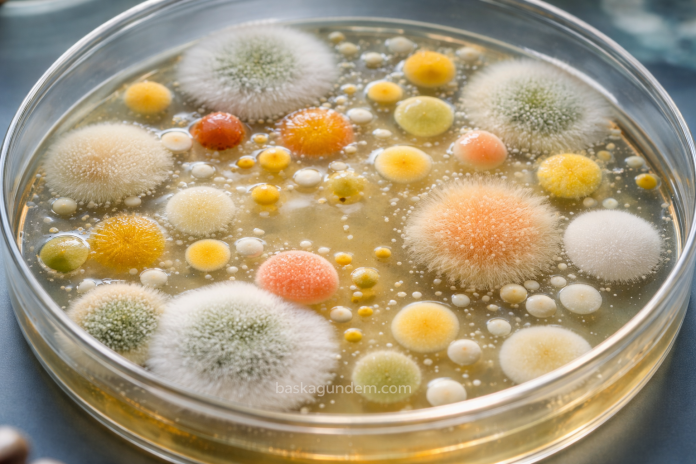
Mikrobiyal Koloniler - Başka Gündem - baskagundem.com

Yeni keşfedilen eski mikrobiyal kolonilere ait fosil izleri, araştırmacıların en eski yaşam formlarını bulma arayışlarını daha derin ve daha kararsız bölgelere yönlendirmeleri gerektiğini gösteriyor. Fas’taki Orta Yüksek Atlas Dağları’nda bulunan bu kırışık fosil yapıları, denizaltı toprak kaymaları tarafından oluşturulan türbiditler üzerinde yer alıyor. Araştırmacılar, bugünkü mikrobiyal paspasların genellikle ışığın dalgalar aracılığıyla süzüldüğü sığ sularda büyüdüğü düşünüldüğünde, bu imzaları türbiditler üzerinde görmeyi beklemiyorlardı.
Fas türbiditleri, 180 milyon yıl önce oluştuklarında, yüzeyin en az 180 metre altında yer alıyordu. Texas Üniversitesi’nden jeobiyolog Rowan Martindale, bu tür kırışık yapıların derin su ortamlarında olmamaları gerektiğini belirtti. Bu dikkate değer keşif, Martindale önderliğindeki bir ekibin Fas’ın Dadès Vadisi’nde kadim resifleri incelerken neredeyse tesadüfen bulduğu fosiller ile ilgili olarak Geology dergisinde yayınlanan bir makalede detaylandırıldı.
Fosiller, ışık içermeyen bir ortamda var olamayacaklarından, fotosentetik olamazlardı. Yapılan kimyasal analiz, bu kaya katmanlarında yüksek miktarda karbon içerdiklerini ve bu durumun kırışıklıkların yaşam ile oluştuğuna işaret ettiğini ortaya koydu. Martindale ve ekibi, bu yaşamın muhtemelen kemotrofik olduğunu, yani enerjisini kimyasal reaksiyonlarla sağladığını belirtti. Bugün, kemotrofik mikrobiyal paspaslar kıta sahanlıklarında, denizaltı heyelanları ve türbiditlerin de meydana geldiği yerlerde oluşmaktadır.
Araştırma ekibi, denizaltı kaymalarının organik materyalleri deniz tabanına taşıyarak bu mikroorganizmaların hayatta kalmasını sağladığını, bu materyallerin ise metan veya hidrojen sülfür gibi kimyasallara dönüştüğünü keşfetti. Bu kimyasallar, kemotrofik yaşam için besin kaynağı oluşturdu. Kimi zaman bu mikrobiyal yapıların izleri silinirken, bazı durumlarda korunarak günümüze kadar geliyor.
Bu buluş, bilim insanlarının kırışık yapıların izlerini ararken dikkati sığ yapılardan, derin suların oluşturduğu kayalıklara genişletmesi gerektiğini gösteriyor. Bu yaklaşım, en eski kemotrofik organizmalar hakkında daha fazla bilgi elde etmelerini sağlayabilir. Martindale, kırışık yapıların yaşamın erken evrimi için kritik kanıtlar sunduğunu vurguluyor.